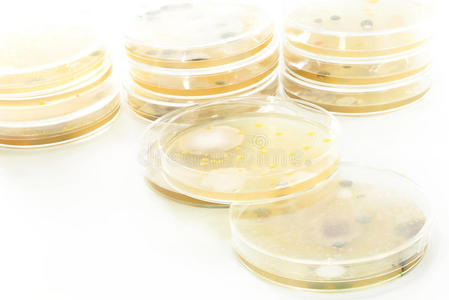
疫霉菌图片

疫霉菌

新疆野苹果林中疫霉菌种类鉴定及致病性研究
图片尺寸700x552
杨凌龙德盛草莓苗:草莓苗出现疫霉菌症状,应该怎么防治?
图片尺寸640x452
超清晰疫霉果腐病病原图片
图片尺寸690x520
霉菌其他生物学相关
图片尺寸800x600
试验,相容试验,盆栽试验从6株生防菌中筛选对烟草疫霉菌(phytophthora
图片尺寸943x375
霉菌图片
图片尺寸400x300
p>辣椒疫霉,在ca上菌落呈放射状,絮状, a href="#" data-lemmaid="
图片尺寸1024x700
对免疫系统的危害:霉菌毒素能干扰赛鸽免疫系统,引起淋巴器官,胸腺
图片尺寸1080x720
霉菌图片
图片尺寸494x300
疫霉菌图片
图片尺寸718x300
疫霉菌图片
图片尺寸449x300
疫霉菌
图片尺寸116x160
雨季荔枝杀手荔枝霜疫霉病
图片尺寸1280x650
p>豇豆疫霉 ,菌类.
图片尺寸1276x1601
再看看有害菌——霉菌
图片尺寸1200x1600
大豆腐图片
图片尺寸419x300
烟草疫霉菌纳米氧化铜抗菌剂及其制备方法与流程
图片尺寸1000x839
马铃薯晚疫病卵菌病害中最重要的三种类型分别是霜霉病,疫霉病和腐
图片尺寸800x561
芋疫霉
图片尺寸1588x2138
霉菌
图片尺寸703x583